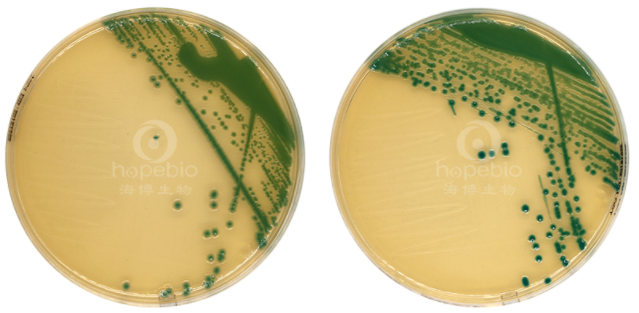

海博微信公众号
海博天猫旗舰店




一、克罗诺杆菌属情况简要介绍
克罗诺杆菌属(Cronobacter)属于肠杆菌科,革兰氏阴性杆状菌,(0.6~1.0)μm×(1.2~3.0)μm。不形成芽孢,无荚膜,形成周生鞭毛。需氧或兼性厌氧,最适温度为30℃~37℃。37℃培养18h~24h菌落圆形、微凸、光滑湿润、黄色、边缘整齐,直径为2mm~3mm。
克罗诺杆菌属广泛分布于自然界中,在食品、饮料、加工原料、生产环境等都能分离到该菌。克罗诺杆菌属与散发的或小规模暴发的败血症、脑膜炎、大脑炎、坏死性小肠结肠炎相关。大多数感染被发现于低体重新生儿(如低于2kg)或者早产儿(即妊娠少于37周)。报道死亡率高达50%,但近年来已经降低到20%。克罗诺杆菌的传染源目前还不清楚。但在生产奶粉和其他食品的工厂或家庭中被频繁地检测到。商业生产的未消毒婴儿配方奶粉常被作为该菌暴发时的感染源。虽然婴儿配方奶粉以外的传染源尚未被发现,但是在环境中的传染源可能还是存在的。
二、参考标准
《GB 4789.40-2016 食品安全国家标准 食品微生物学检验 克罗诺杆菌属(阪崎肠杆菌)检验》点击下载
三、检验方法以及结果分析
第一法克罗诺杆菌属定性检验
3.1检验程序
克罗诺杆菌属检验程序见图1。
图1 克罗诺杆菌属检验程序
3.2操作步骤
3.2.1 前增菌和增菌
取检样100g(mL)置灭菌锥形瓶中,加入900mL已预热至44℃的缓冲蛋白胨水,用手缓缓地摇动至充分溶解,36℃±1℃培养18h±2h。移取1mL转种于10mL mLST-Vm(改良月桂基硫酸盐胰蛋白胨肉汤-万古霉素)肉汤,44℃±0.5℃培养24h±2h。
质控菌株接种到mLST-Vm肉汤中,培养结果如下图所示:
图2 不同细菌在mLST-Vm肉汤上的生长情况
3.2.2 分离
轻轻混匀mLST-Vm肉汤培养物,各取增菌培养物1环,分别划线接种于两个阪崎肠杆菌显色培养基平板,显色培养基须符合GB4789.28的要求,36℃±1℃培养24 h±2 h,或按培养基要求条件培养。
阪崎肠杆菌划线接种到海博阪崎肠杆菌显色培养基平板,培养结果如下图所示:
|
阪崎肠杆菌ATCC 29544 阪崎肠杆菌CICC 10318 |
图3 阪崎肠杆菌在阪崎肠杆菌显色培养基平板上的菌落特征
挑取至少5个可疑菌落,不足5个时挑取全部可疑菌落,划线接种于TSA平板。25℃±1℃培养48h±4h。
阪崎肠杆菌接种到TSA平板,有黄色素产生,培养结果如下图所示:
图4 阪崎肠杆菌在TSA平板上的菌落特征
3.2.3 鉴定
自TSA平板上直接挑取黄色可疑菌落,进行生化鉴定。可选择生化鉴定试剂盒或全自动微生物生化鉴定系统。
阪崎肠杆菌氧化酶为阴性,2min内不变色,结果如下图所示:
图4 阪崎肠杆菌氧化酶试验结果
阪崎肠杆菌接种至HBI阪崎肠杆菌生化鉴定条(GB),结果如下图所示:
图5 阪崎肠杆菌在HBI阪崎肠杆菌生化鉴定条(GB)上的结果
克罗诺杆菌属的主要生化特征见下表。
表1 克罗诺杆菌属的主要生化特征
|
生化试验 |
特征 |
|
|
黄色素产生 |
+ |
|
|
氧化酶 |
- |
|
|
L-赖氨酸脱羧酶 |
- |
|
|
L-鸟氨酸脱羧酶 |
(+) |
|
|
L-精氨酸双水解酶 |
+ |
|
|
柠檬酸水解 |
(+) |
|
|
发酵 |
D-山梨醇 |
(-) |
|
L-鼠李糖 |
+ |
|
|
D-蔗糖 |
+ |
|
|
D-蜜二糖 |
+ |
|
|
苦杏仁甙 |
+ |
|
|
注:+>99%阳性;->99%阴性; (+)90%~99%阳性;(-)90%~99%阴性。 |
||
3.3结果与报告
综合菌落形态和生化特征,报告每100 g(mL)样品中检出或未检出克罗诺杆菌属。
第二法克罗诺杆菌属的计数
3.4操作步骤
3.4.1 样品的稀释
固体和半固体样品:无菌称取样品100g、10g、1g各三份,分别加入900mL、90mL、9mL已预热至44℃的BPW,轻轻振摇使充分溶解,制成1:10样品匀液,置36℃±1℃培养18h±2h。分别移取1mL转种于10mL mLST-Vm肉汤,44℃±0.5℃培养24h±2h。
液体样品:以无菌吸管分别取样品100mL、10mL、1mL各三份,分别加入900mL、90mL、9mL已预热至44℃的BPW,轻轻振摇使充分混匀,制成1:10样品匀液,置36℃±1℃培养18h±2h。分别移取1mL转种于10mL mLST-Vm肉汤,44℃±0.5℃培养24h±2h。
3.4.2 分离、鉴定
同3.2.2和3.2.3。
3.5结果与报告
综合菌落形态、生化特征,根据证实为克罗诺杆菌属的阳性管数,查MPN检索表,报告每100g(mL)样品中克罗诺杆菌属的MPN值(见下表)。
表2 克罗诺杆菌属最可能数(MPN)检索表
相关标准:
GB 4789.40-2016 克罗诺杆菌属(阪崎肠杆菌)检验 点击下载
注:本文属海博生物原创,未经允许不得转载。
